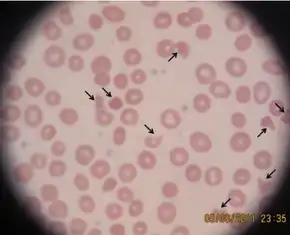

Thrombotic thrombocytopenic purpura
| Thrombotic thrombocytopenic purpura | |
|---|---|
| Other names: Moschcowitz syndrome,[1] idiopathic thrombotic thrombocytopenic purpura[2] | |
![]() | |
| Spontaneous bruising in a woman with critical low platelets | |
| Specialty | Hematology |
| Symptoms | Large bruises, fever, weakness, shortness of breath, confusion, headache[3][2] |
| Usual onset | Adulthood[3] |
| Causes | Unknown, bacterial infections, certain medications, autoimmune diseases, pregnancy[3] |
| Diagnostic method | Based on symptoms and blood tests[2] |
| Differential diagnosis | Hemolytic-uremic syndrome (HUS), atypical hemolytic uremic syndrome (aHUS)[4] |
| Treatment | Plasma exchange, immunosuppressants[1] |
| Prognosis | < 20% risk of death[1] |
| Frequency | 1 in 100,000 people[3] |
Thrombotic thrombocytopenic purpura (TTP) is a blood disorder that results in blood clots forming in small blood vessels throughout the body.[2] This results in a low platelet count, low red blood cells due to their breakdown, and often kidney, heart, and brain dysfunction.[1] Symptoms may include large bruises, fever, weakness, shortness of breath, confusion, and headache.[2][3] Repeated episodes may occur.[3]
In about half of cases a trigger is identified, while in the remainder the cause remains unknown.[3] Known triggers include bacterial infections, certain medications, autoimmune diseases such as lupus, and pregnancy.[3] The underlying mechanism typically involves antibodies inhibiting the enzyme ADAMTS13.[1] This results in decreased break down of large multimers of von Willebrand factor (vWF) into smaller units.[1] Less commonly TTP is inherited from a person's parents, known as Upshaw–Schulman syndrome, such that ADAMTS13 dysfunction is present from birth.[5] Diagnosis is typically based on symptoms and blood tests.[2] It may be supported by measuring activity of or antibodies against ADAMTS13.[2]
With plasma exchange the risk of death has decreased from more than 90% to less than 20%.[1] Immunosuppressants, such as glucocorticoids, and rituximab may also be used.[3] Platelet transfusions are generally not recommended.[6]
About 1 per 100,000 people are affected.[3] Onset is typically in adulthood and women are more often affected.[3] About 10% of cases begin in childhood.[3] The condition was first described by Eli Moschcowitz in 1924.[3] The underlying mechanism was determined in the 1980s and 1990s.[3]
Signs and symptoms
The signs and symptoms of TTP may at first be subtle and nonspecific. Many people experience an influenza-like or diarrheal illness before developing TTP.[7] Neurological symptoms are very common and vary greatly in severity. Frequently reported symptoms include feeling very tired, confusion, and headaches.[7] Seizures and symptoms similar to those of a stroke can also be seen.[7] Other symptoms include, but are not limited to jaundice or paleness of the skin, a fast heart rate or shortness of breath, or pinpoint-sized purple or reddish dots on the skin known as petechiae.
As TTP progresses, blood clots form within small blood vessels (microvasculature), and platelets (clotting cells) are consumed. As a result, bruising, and rarely bleeding can occur. The bruising often takes the form of purpura, while the most common site of bleeding, if it occurs, is from the nose or gums. Larger bruises (ecchymoses) may also develop. The classic presentation of TTP, which occurs in less than 10% of people, includes five medical signs.[3] These are:
- Fever
- Changes in mental status
- Thrombocytopenia
- Reduced kidney function
- Haemolytic anaemia (microangiopathic hemolytic anemia).[7]
High blood pressure (hypertension) may be found on examination.[8]
Causes
TTP, as with other microangiopathic hemolytic anemias (MAHAs), is caused by spontaneous aggregation of platelets and activation of coagulation in the small blood vessels. Platelets are consumed in the aggregation process and bind vWF. These platelet-vWF complexes form small blood clots which circulate in the blood vessels and cause shearing of red blood cells, resulting in their rupture and formation of schistocytes.[9] The two best understood causes of TTP are due to autoimmunity and an inherited deficiency of ADAMTS13 (known as the Upshaw-Schülman syndrome).[9] The majority of the remaining cases are secondary to some other factor.
Autoimmune
TTP of unknown cause was long known as idiopathic TTP but in 1998 the majority of cases were shown to be caused by the inhibition of the enzyme ADAMTS13 by antibodies. The relationship of reduced ADAMTS13 to the pathogenesis of TTP is known as the Furlan-Tsai hypothesis, after the two independent groups of researchers who published their research in the same issue of the New England Journal of Medicine.[10][11][12] These cases are now classed as an autoimmune disease and are known as autoimmune TTP (not to be confused with immune/idiopathic thrombocytopenic purpura).
ADAMTS13 is a metalloproteinase responsible for the breakdown of von Willebrand factor (vWF), a protein that links platelets, blood clots, and the blood vessel wall in the process of blood coagulation. Very large vWF multimers are more prone to lead to coagulation. Hence, without proper cleavage of vWF by ADAMTS13, coagulation occurs at a higher rate, especially in the microvasculature, part of the blood vessel system where vWF is most active due to high shear stress.[5] In idiopathic TTP, severely decreased (<5% of normal) ADAMTS13 activity can be detected in most (80%) people, and inhibitors are often found in this subgroup (44–56%).
Genetic

This condition may also be congenital. Such cases may be caused by mutations in the ADAMTS13 gene.[15] This hereditary form of TTP is called the Upshaw–Schulman syndrome.[16][17][18] People with this inherited ADAMTS13 deficiency have a surprisingly mild phenotype, but develop TTP in clinical situations with increased von Willebrand factor levels, e.g. infection. Reportedly, less than 1% of all TTP cases are due to Upshaw–Schulman syndrome.[19] People with this syndrome generally have 5–10% of normal ADAMTS-13 activity.[18][20]
Secondary
Secondary TTP is diagnosed when the person's history mentions one of the known features associated with TTP. It comprises about 40% of all cases of TTP. Predisposing factors are:[9]
- Cancer
- Bone marrow transplantation
- Pregnancy
- Medication use:
- Antiviral drugs (acyclovir)
- Certain chemotherapy medications such as gemcitabine and mitomycin C
- Quinine
- Oxymorphone
- Quetiapine
- Bevacizumab
- Sunitinib
- Platelet aggregation inhibitors (ticlopidine, clopidogrel, and prasugrel)
- Immunosuppressants (ciclosporin, mitomycin, tacrolimus/FK506, interferon-α)
- Hormone altering drugs (estrogens, contraceptives, hormone replacement therapy)[21]
- HIV-1 infection
The mechanism of secondary TTP is poorly understood, as ADAMTS13 activity is generally not as depressed as in idiopathic TTP, and inhibitors cannot be detected. Probable etiology may involve, at least in some cases, endothelial damage,[22] although the formation of thrombi resulting in vessel occlusion may not be essential in the pathogenesis of secondary TTP.[23] These factors may also be considered a form of secondary aHUS; people presenting with these features are, therefore, potential candidates for anticomplement therapy.
Mechanism
The underlying mechanism typically involves autoantibody-mediated inhibition of the enzyme ADAMTS13, a metalloprotease responsible for cleaving large multimers of von Willebrand factor (vWF) into smaller units. The increase in circulating multimers of vWF increases platelet adhesion to areas of endothelial injury, particularly where arterioles and capillaries meet, which in turn results in the formation of small platelet clots called thrombi. As platelets are used up in the formation of thrombi, this then leads to a decrease in the number of overall circulating platelets, which may then cause life-threatening bleeds. Red blood cells passing the microscopic clots are subjected to shear stress, which damages their membranes, leading to rupture of red blood cells within blood vessels, which in turn leads to anaemia and schistocyte formation. The presence of these blood clots in the small blood vessels reduces blood flow to organs resulting in cellular injury and end organ damage.
Diagnosis
The diagnosis of Thrombotic thrombocytopenic purpura is done via the following:[24]
- Blood test
- Blood smear
- Platelet count
- Coombs test
- Urinalysis
Differential diagnosis
TTP is characterized by thrombotic microangiopathy (TMA), the formation of blood clots in small blood vessels throughout the body, which can lead to microangiopathic hemolytic anemia and thrombocytopenia. This characteristic is shared by two related syndromes, hemolytic-uremic syndrome (HUS) and atypical hemolytic uremic syndrome (aHUS).[4] Consequently, differential diagnosis of these TMA-causing diseases is essential. In addition to TMA, one or more of the following symptoms may be present in each of these diseases: neurological symptoms (e.g. confusion,[25][26] cerebral convulsions[26] seizures,[27]); kidney impairment[28] (e.g. elevated creatinine,[29] decreased estimated glomerular filtration rate [eGFR],[29] abnormal urinalysis[30]); and gastrointestinal (GI) symptoms (e.g. diarrhea[25][31] nausea/vomiting,[27] abdominal pain,[27] gastroenteritis.[25][28] Unlike HUS and aHUS, TTP is known to be caused by an acquired defect in the ADAMTS13 protein, so a lab test showing ≤5% of normal ADAMTS13 levels is indicative of TTP.[32] ADAMTS13 levels above 5%, coupled with a positive test for shiga-toxin/enterohemorrhagic E. coli (EHEC), are more likely indicative of HUS,[33] whereas absence of shiga-toxin/EHEC can confirm a diagnosis of aHUS.[32]
Treatment
Due to the high mortality of untreated TTP, a presumptive diagnosis of TTP is made even when only microangiopathic hemolytic anemia and thrombocytopenia are seen, and therapy is started. Transfusion is contraindicated in thrombotic TTP, as it fuels the coagulopathy. Since the early 1990s, plasmapheresis has become the treatment of choice for TTP.[34][35] This is an exchange transfusion involving removal of the person's blood plasma through apheresis and replacement with donor plasma (fresh frozen plasma or cryosupernatant); the procedure must be repeated daily to eliminate the inhibitor and abate the symptoms. If apheresis is not available, fresh frozen plasma can be infused, but the volume that can be given safely is limited due to the danger of fluid overload.[36] Plasma infusion alone is not as beneficial as plasma exchange.[34] Corticosteroids (prednisone or prednisolone) are usually given.[35] Rituximab, a monoclonal antibody aimed at the CD20 molecule on B lymphocytes, may be used on diagnosis; this is thought to kill the B cells and thereby reduce the production of the inhibitor.[35] A stronger recommendation for rituximab exists where TTP does not respond to corticosteroids and plasmapheresis.[35]
Caplacizumab is an alternative option in treating TTP as it has been shown that it induces a faster disease resolution compared with those people who were on placebo.[37] However, the use of caplacizumab was associated with increase bleeding tendencies in the studied subjects.
People with refractory or relapsing TTP may receive additional immunosuppressive therapy, e.g. vincristine, cyclophosphamide, cyclosporine A, or splenectomy.[3][36]
Children with Upshaw-Schülman syndrome receive prophylactic plasma every two to three weeks; this maintains adequate levels of functioning ADAMTS13. Some tolerate longer intervals between plasma infusions. Additional plasma infusions may be necessary for triggering events, such as surgery; alternatively, the platelet count may be monitored closely around these events with plasma being administered if the count drops.[38]
Measurements of blood levels of lactate dehydrogenase, platelets, and schistocytes are used to monitor disease progression or remission. ADAMTS13 activity and inhibitor levels may be measured during follow-up, but in those without symptoms the use of rituximab is not recommended.[35]
Prognosis
The mortality rate is around 95% for untreated cases, but the prognosis is reasonably favorable (80–90% survival) for people with idiopathic TTP diagnosed and treated early with plasmapheresis.[39]
Epidemiology
The incidence of TTP is about 4–5 cases per million people per year.[40] Idiopathic TTP occurs more often in women and people of African descent, and TTP secondary to autoimmune disorders such as systemic lupus erythematosus occurs more frequently in people of African descent, although other secondary forms do not show this distribution.[41] Pregnant women and women in the post partum period accounted for a notable portion (12–31%) of the cases in some studies; TTP affects about one in 25,000 pregnancies.[42]
History
TTP was initially described by Eli Moschcowitz at the Beth Israel Hospital in New York City in 1925. Moschcowitz ascribed the disease (incorrectly, as now known) to a toxic cause. Moschcowitz noted his patient, a 16-year-old girl, had anemia, small and large bruises, microscopic hematuria, and, at autopsy, disseminated microvascular thrombi.[43] In 1966, a review of 16 new cases and 255 previously reported cases led to the formulation of the classical pentad of symptoms and findings (i.e., thrombocytopenia, microangiopathic hemolytic anemia, neurological symptoms, kidney failure, fever); in this series, mortality rates were found to be very high (90%).[44]
While a response to blood transfusion had been noted before, a 1978 report and subsequent studies showed blood plasma was highly effective in improving the disease process.[45] In 1991, plasma exchange was reported to provide better response rates compared to plasma infusion.[46] In 1982, the disease had been linked with abnormally large von Willebrand factor multimers. The identification of a deficient protease in people with TTP was made in 1998s. The location of ADAMTS13 within the human genome was identified in 2001.[45]
References
- ↑ 1.0 1.1 1.2 1.3 1.4 1.5 1.6 Kremer Hovinga, JA; Coppo, P; Lämmle, B; Moake, JL; Miyata, T; Vanhoorelbeke, K (6 April 2017). "Thrombotic thrombocytopenic purpura". Nature Reviews. Disease Primers. 3: 17020. doi:10.1038/nrdp.2017.20. PMID 28382967. S2CID 11960153.
- ↑ 2.0 2.1 2.2 2.3 2.4 2.5 2.6 "Thrombotic thrombocytopenic purpura, acquired". Genetic and Rare Diseases Information Center (GARD) – an NCATS Program. Archived from the original on 20 October 2018. Retrieved 10 October 2018.
- ↑ 3.00 3.01 3.02 3.03 3.04 3.05 3.06 3.07 3.08 3.09 3.10 3.11 3.12 3.13 3.14 3.15 Joly, BS; Coppo, P; Veyradier, A (25 May 2017). "Thrombotic thrombocytopenic purpura". Blood. 129 (21): 2836–2846. doi:10.1182/blood-2016-10-709857. PMID 28416507.
- ↑ 4.0 4.1 George JN (November 2010). "How I treat patients with thrombotic thrombocytopenic purpura: 2010". Blood. 116 (20): 4060–9. doi:10.1182/blood-2010-07-271445. PMID 20686117.
- ↑ 5.0 5.1 Moake JL (2004). "von Willebrand factor, ADAMTS-13, and thrombotic thrombocytopenic purpura". Semin. Hematol. 41 (1): 4–14. doi:10.1053/j.seminhematol.2003.10.003. PMID 14727254.
- ↑ Wood, Marie E.; Philips, George K. (2003). Hematology/oncology Secrets. Elsevier Health Sciences. p. 68. ISBN 978-1560535164. Archived from the original on 2021-08-29. Retrieved 2020-07-24.
- ↑ 7.0 7.1 7.2 7.3 Shatzel, JJ; Taylor, JA (March 2017). "Syndromes of Thrombotic Microangiopathy". The Medical Clinics of North America (Review). 101 (2): 395–415. doi:10.1016/j.mcna.2016.09.010. PMID 28189178.
- ↑ Allford S, Machin S (2005). "Thrombotic thrombocytopenic purpura". NetDoctor.co.uk. Archived from the original on 2015-09-18. Retrieved 2004-05-14.
- ↑ 9.0 9.1 9.2 Moake JL (2002). "Thrombotic microangiopathies". N. Engl. J. Med. 347 (8): 589–600. doi:10.1056/NEJMra020528. PMID 12192020.
- ↑ Moake JL (1998). "Moschcowitz, multimers, and metalloprotease". N. Engl. J. Med. 339 (22): 1629–31. doi:10.1056/NEJM199811263392210. PMID 9828253.
- ↑ Furlan M; Robles R; Galbusera M; et al. (1998). "von Willebrand factor-cleaving protease in thrombotic thrombocytopenic purpura and the hemolytic-uremic syndrome". N. Engl. J. Med. 339 (22): 1578–84. doi:10.1056/NEJM199811263392202. PMID 9828245.
- ↑ Tsai HM, Lian EC (1998). "Antibodies to von Willebrand factor–cleaving protease in acute thrombotic thrombocytopenic purpura". N. Engl. J. Med. 339 (22): 1585–94. doi:10.1056/NEJM199811263392203. PMC 3159001. PMID 9828246.
- ↑ "OMIM Entry - # 274150 - THROMBOTIC THROMBOCYTOPENIC PURPURA, CONGENITAL; TTP". www.omim.org. Archived from the original on 6 May 2017. Retrieved 23 October 2017.
- ↑ RESERVED, INSERM US14 -- ALL RIGHTS. "Orphanet: Thrombotic thrombocytopenic purpura". www.orpha.net. Archived from the original on 15 June 2018. Retrieved 23 October 2017.
{{cite web}}: CS1 maint: numeric names: authors list (link) - ↑ Conboy E, Partain PI, Warad D, Kluge ML, Arndt C, Chen D, Rodriguez V (2017) A severe case of congenital thrombotic thrombocytopenia purpura resulting from compound heterozygosity involving a novel ADAMTS13 pathogenic variant. J Pediatr Hematol Oncol
- ↑ Schulman I, Pierce M, Lukens A, Currimbhoy Z (July 1960). "Studies on thrombopoiesis. I. A factor in normal human plasma required for platelet production; chronic thrombocytopenia due to its deficiency" (PDF). Blood. 16 (1): 943–57. doi:10.1182/blood.V16.1.943.943. PMID 14443744. Archived from the original on 2007-11-16. Retrieved 2008-07-13.
- ↑ Upshaw JD (June 1978). "Congenital deficiency of a factor in normal plasma that reverses microangiopathic hemolysis and thrombocytopenia". N. Engl. J. Med. 298 (24): 1350–2. doi:10.1056/NEJM197806152982407. PMID 651994.
- ↑ 18.0 18.1 Levy GG, Nichols WC, Lian EC, Foroud T, McClintick JN, McGee BM, Yang AY, Siemieniak DR, Stark KR, Gruppo R, Sarode R, Shurin SB, Chandrasekaran V, Stabler SP, Sabio H, Bouhassira EE, Upshaw JD, Ginsburg D, Tsai HM, et al. (October 2001). "Mutations in a member of the ADAMTS gene family cause thrombotic thrombocytopenic purpura" (PDF). Nature. 413 (6855): 488–494. Bibcode:2001Natur.413..488L. doi:10.1038/35097008. hdl:2027.42/62592. PMID 11586351. S2CID 4380010. Archived from the original on 2021-08-29. Retrieved 2019-09-01.
- ↑ Tsai HM (2009). "Thrombotic thrombocytopenic purpura, hemolytic uremic syndrome, and related disorders". In Greer JP, Foerster J, Rodgers GM, et al. (eds.). Wintrobe's Clinical Hematology (12th ed.). Philadelphia PA: Lippincott, Williams, and Wilkins. pp. 1314–25. ISBN 978-0781765077.
- ↑ Kokame, K.; Matsumoto, M; Soejima, K; Yagi, H; Ishizashi, H; Funato, M; Tamai, H; Konno, M; Kamide, K; Kawano, Y; Miyata, T; Fujimura, Y (14 August 2002). "Mutations and common polymorphisms in ADAMTS13 gene responsible for von Willebrand factor-cleaving protease activity". Proc. Natl. Acad. Sci. USA. 99 (18): 11902–7. Bibcode:2002PNAS...9911902K. doi:10.1073/pnas.172277399. PMC 129366. PMID 12181489.
- ↑ Menkes, John H.; Sarnat, Harvey B.; Maria, Bernard L. (2006). "Thrombotic Thrombocytopenic Purpura and Hemolytic-Uremic Syndrome". Child Neurology (7th ed.). Philadelphia: Lippincott Williams & Wilkins. p. 525. ISBN 9780781751049.
- ↑ van Mourik JA, Boertjes R, Huisveld IA, et al. (July 1999). "von Willebrand factor propeptide in vascular disorders: A tool to distinguish between acute and chronic endothelial cell perturbation". Blood. 94 (1): 179–85. doi:10.1182/blood.V94.1.179.413k18_179_185. PMID 10381511. Archived from the original on 2020-02-24. Retrieved 2014-04-23.
- ↑ Iwata H, Kami M, Hori A, Hamaki T, Takeuchi K, Mutou Y (June 2001). "An autopsy-based retrospective study of secondary thrombotic thrombocytopenic purpura". Haematologica. 86 (6): 669–70. PMID 11418383. Archived from the original on 2021-08-29. Retrieved 2014-04-23.
- ↑ "Thrombotic thrombocytopenic purpura: MedlinePlus Medical Encyclopedia". medlineplus.gov. Archived from the original on 14 December 2022. Retrieved 16 March 2023.
- ↑ 25.0 25.1 25.2 Noris M, Caprioli J, Bresin E, et al. (October 2010). "Relative role of genetic complement abnormalities in sporadic and familial aHUS and their impact on clinical phenotype". Clin J Am Soc Nephrol. 5 (10): 1844–59. doi:10.2215/CJN.02210310. PMC 2974386. PMID 20595690. Archived from the original on 2020-04-14. Retrieved 2014-04-23.
- ↑ 26.0 26.1 Neuhaus TJ, Calonder S, Leumann EP (June 1997). "Heterogeneity of atypical haemolytic uraemic syndromes". Arch. Dis. Child. 76 (6): 518–21. doi:10.1136/adc.76.6.518. PMC 1717216. PMID 9245850.
- ↑ 27.0 27.1 27.2 Dragon-Durey MA, Sethi SK, Bagga A, et al. (December 2010). "Clinical features of anti-factor H autoantibody-associated hemolytic uremic syndrome". J. Am. Soc. Nephrol. 21 (12): 2180–7. doi:10.1681/ASN.2010030315. PMC 3014031. PMID 21051740. Archived from the original on 2020-04-14. Retrieved 2014-04-23.
- ↑ 28.0 28.1 Caprioli J, Noris M, Brioschi S, et al. (August 2006). "Genetics of HUS: the impact of MCP, CFH, and IF mutations on clinical presentation, response to treatment, and outcome". Blood. 108 (4): 1267–79. doi:10.1182/blood-2005-10-007252. PMC 1895874. PMID 16621965.
- ↑ 29.0 29.1 Ariceta G, Besbas N, Johnson S, et al. (April 2009). "Guideline for the investigation and initial therapy of diarrhea-negative hemolytic uremic syndrome". Pediatr. Nephrol. 24 (4): 687–96. doi:10.1007/s00467-008-0964-1. PMID 18800230.
- ↑ Al-Akash SI, Almond PS, Savell VH, Gharaybeh SI, Hogue C (April 2011). "Eculizumab induces long-term remission in recurrent post-transplant HUS associated with C3 gene mutation". Pediatr. Nephrol. 26 (4): 613–9. doi:10.1007/s00467-010-1708-6. PMID 21125405. S2CID 22334044.
- ↑ Zuber J, Le Quintrec M, Sberro-Soussan R, Loirat C, Frémeaux-Bacchi V, Legendre C (January 2011). "New insights into postrenal transplant hemolytic uremic syndrome". Nat Rev Nephrol. 7 (1): 23–35. doi:10.1038/nrneph.2010.155. PMID 21102542. S2CID 2054556.
- ↑ 32.0 32.1 Tsai HM (January 2010). "Pathophysiology of thrombotic thrombocytopenic purpura". Int. J. Hematol. 91 (1): 1–19. doi:10.1007/s12185-009-0476-1. PMC 3159000. PMID 20058209.
- ↑ Bitzan M, Schaefer F, Reymond D (September 2010). "Treatment of typical (enteropathic) hemolytic uremic syndrome". Semin. Thromb. Hemost. 36 (6): 594–610. doi:10.1055/s-0030-1262881. PMID 20865636.
- ↑ 34.0 34.1 Michael, M; Elliott, EJ; Ridley, GF; Hodson, EM; Craig, JC (21 January 2009). "Interventions for haemolytic uraemic syndrome and thrombotic thrombocytopenic purpura". The Cochrane Database of Systematic Reviews (1): CD003595. doi:10.1002/14651858.CD003595.pub2. hdl:10072/61440. PMC 7154575. PMID 19160220.
- ↑ 35.0 35.1 35.2 35.3 35.4 Lim W, Vesely SK, George JN (5 March 2015). "The role of rituximab in the management of patients with acquired thrombotic thrombocytopenic purpura". Blood. 125 (10): 1526–31. doi:10.1182/blood-2014-10-559211. PMC 4351502. PMID 25573992.
- ↑ 36.0 36.1 Allford SL, Hunt BJ, Rose P, Machin SJ (February 2003). "Guidelines on the diagnosis and management of the thrombotic microangiopathic haemolytic anaemias". Br. J. Haematol. 120 (4): 556–73. doi:10.1046/j.1365-2141.2003.04049.x. PMID 12588343. S2CID 38774829.
- ↑ Peyvandi, Flora; Scully, Marie; Kremer Hovinga, Johanna A.; Cataland, Spero; Knöbl, Paul; Wu, Haifeng; Artoni, Andrea; Westwood, John-Paul; Mansouri Taleghani, Magnus (2016-02-11). "Caplacizumab for Acquired Thrombotic Thrombocytopenic Purpura" (PDF). New England Journal of Medicine. 374 (6): 511–522. doi:10.1056/NEJMoa1505533. ISSN 0028-4793. PMID 26863353. Archived (PDF) from the original on 2020-02-11. Retrieved 2019-07-12.
- ↑ Loirat, C; Girma, JP; Desconclois, C; Coppo, P; Veyradier, A (January 2009). "Thrombotic thrombocytopenic purpura related to severe ADAMTS13 deficiency in children". Pediatric Nephrology (Berlin, Germany). 24 (1): 19–29. doi:10.1007/s00467-008-0863-5. PMID 18574602. S2CID 22209831.
- ↑ Tsai, Han-Mou (February 2006). "Current Concepts in Thrombotic Thrombocytopenic Purpura". Annual Review of Medicine. 57: 419–436. doi:10.1146/annurev.med.57.061804.084505. PMC 2426955. PMID 16409158.
- ↑ Terrell DR, Williams LA, Vesely SK, Lämmle B, Hovinga JA, George JN (July 2005). "The incidence of thrombotic thrombocytopenic purpura-hemolytic uremic syndrome: all patients, idiopathic patients, and patients with severe ADAMTS-13 deficiency". J. Thromb. Haemost. 3 (7): 1432–6. doi:10.1111/j.1538-7836.2005.01436.x. PMID 15978100.
- ↑ Terrell DR, Vesely SK, Kremer Hovinga JA, Lämmle B, George JN (November 2010). "Different disparities of gender and race among the thrombotic thrombocytopenic purpura and hemolytic-uremic syndromes". Am. J. Hematol. 85 (11): 844–7. doi:10.1002/ajh.21833. PMC 3420337. PMID 20799358.
- ↑ X. Long Zheng; J. Evan Sadler (2008). "Pathogenesis of Thrombotic Microangiopathies". Annual Review of Pathology. 3: 249–277. doi:10.1146/annurev.pathmechdis.3.121806.154311. PMC 2582586. PMID 18215115.
- ↑ Moschcowitz E (1924). "An acute febrile pleiochromic anemia with hyaline thrombosis of the terminal arterioles and capillaries: an undescribed disease". Proc NY Pathol Soc. 24: 21–4. Reprinted in Moschcowitz E (October 2003). "An acute febrile pleiochromic anemia with hyaline thrombosis of the terminal arterioles and capillaries: an undescribed disease. 1925". Mt. Sinai J. Med. 70 (5): 352–5. PMID 14631522..
- ↑ Amorosi EL, Ultmann JE (1966). "Thrombocytopic purpura: report of 16 cases and review of the literature". Medicine (Baltimore). 45 (2): 139–159. doi:10.1097/00005792-196603000-00003. S2CID 71943329.
- ↑ 45.0 45.1 Sadler, JE (2008). "Von Willerbrand factor, ADAMTS13, and thrombotic thrombocytopenic purpura". Blood. 112 (1): 11–18. doi:10.1182/blood-2008-02-078170. PMC 2435681. PMID 18574040.
- ↑ Rock GA; Shumak KH; Buskard NA; et al. (August 1991). "Comparison of plasma exchange with plasma infusion in the treatment of thrombotic thrombocytopenic purpura. Canadian Apheresis Study Group". N. Engl. J. Med. 325 (6): 393–7. doi:10.1056/NEJM199108083250604. PMID 2062330.
External links
| Classification | |
|---|---|
| External resources |
